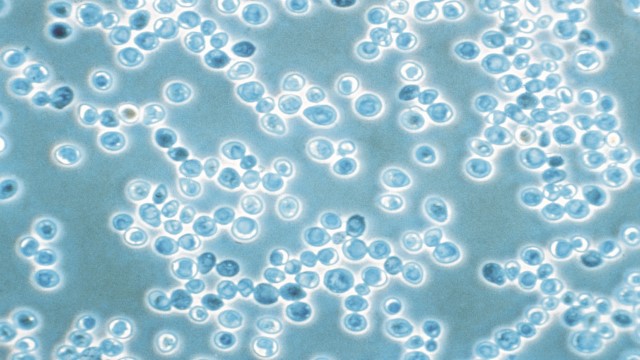

Coldblock - challenges and solutions
Yeast management and fermentation
Yeast management and fermentation are essential parts of the cold block. Equipment to prevent contamination and ensure high yeast viability is essential for a consistent, reliable and effective fermentation process.
Challenges
- High cost
- Reliance on commercial yeast strains
- Limited opportunity for creativity
Solutions
- Yeast Management Systems:
- Alfa Laval 3-in-1 yeast module, or
- Alfa Laval Yeast propagation plant
Outcome
- Ability to rehydrate, propagate and re-use yeast
- Fully customizable solution
Challenge
- Inconsistent or slow fermentation profile
Solution
Outcome
- Up to 40% faster fermentation
- Improved homogenization during fermentation
- Optimized alcohol extract yield
- Flexibility – mobile unit that can be moved between tanks
Challenges
- Long sedimentation time
- High beer loss
- High turbidity
- Low yield
- Need to grow production capacity
Outcome
- Increased production capacity owing to speed of clarification without the need to expand fermenting capacity
- Beer recovery up to 15% compared with draining
- Ability to clarify beer when profile is right
- Extended shelf-life unblemished by haze (especially important for exports)
- Fast emptying of separators also means higher rotation of tanks which provides extra capacity without further investment
- Average 3% increase in yield between fermenting vessel and bright beer tank depending on operating procedures
- Up to 8% yield improvement in low to medium flocculating yeast strains
Dry hopping
Dry hopping is the process of adding hops following fermentation to add more aroma to the beer. Traditionally, dry hopping is done in beer styles such as pale ales and IPAs but is being utilized in the brewing of other beer styles as well.

Challenge
- Slow process and beer loss
Solutions
- Alfa Laval dry hopping equipment:
Outcome
- Maximized use of hops
- Accelerated dry hopping process
- Homogenization of beer streams to improve downstream hop removal via centrifugation